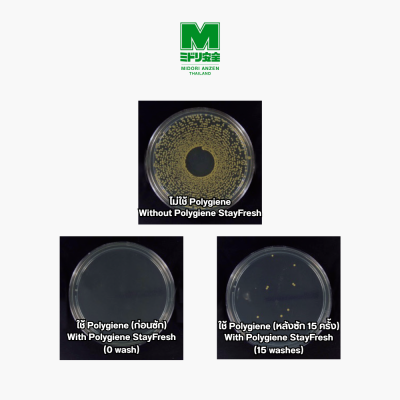
เสื้อยืด Polygiene StayFresh (Pre-Order)

เสื้อยืด Polygiene StayFresh (Pre-Order)
SKU : Polygiene
ขายแล้ว 0 ชิ้น
ยังไม่มีรีวิว
฿350
คำอธิบายสินค้าแบบย่อ
Polygiene StayFresh - เทคโนโลยีที่จะช่วยให้เสื้อของคุณสะอาดสดชื่นและไร้กลิ่น
Pre-order 7-14 days
Polygiene StayFresh คือเทคโนโลยีที่ถูกฝังอยู่ในเนื้อผ้า เพื่อมอบความสดชื่นยาวนานตลอดอายุการใช้งานของผลิตภัณฑ์ส่วนใหญ่ ช่วยลดการสะสมของแบคทีเรียที่เป็นสาเหตุของกลิ่นไม่พึงประสงค์ ทำให้เสื้อผ้าและสิ่งทอคงความสดชื่นและสะอาดได้ยาวนานยิ่งขึ้น เมื่อกลิ่นลดลงจึงไม่จำเป็นต้องซักบ่อย ช่วยประหยัดน้ำและพลังงาน อีกทั้งยังช่วยลดความถี่ในการเปลี่ยนซื้อสินค้าใหม่ ส่งผลดีทั้งต่อผู้ใช้งานและสิ่งแวดล้อม
เทคโนโลยีนี้ถูกใช้งานอย่างแพร่หลายในสินค้าเสื้อผ้ากีฬา เอาท์ดอร์ แฟชั่น ไลฟ์สไตล์ ของใช้ในบ้าน และผลิตภัณฑ์สำหรับสัตว์เลี้ยง โดย Polygiene StayFresh จะยับยั้งการเจริญเติบโตของแบคทีเรียตั้งแต่ต้นตอของกลิ่น แม้ในสภาวะที่มีเหงื่อ ความชื้น หรือความเปียกชื้นอื่น ๆ แบคทีเรียก็ไม่สามารถเพิ่มจำนวนได้ ทำให้สิ่งทอคงความสดใหม่ ถูกสุขอนามัย และสวมใส่ได้อย่างมั่นใจตลอดวัน
เนื่องจากเทคโนโลยีถูกผสานเป็นส่วนหนึ่งของเส้นใยผ้า จึงคงประสิทธิภาพยาวนานตลอดอายุการใช้งานของผลิตภัณฑ์ส่วนใหญ่ มอบความสดชื่นอย่างแท้จริงในระยะยาว
฿350
- หน้าหลัก หน้าหลัก
- เกี่ยวกับเรา เกี่ยวกับเรา
- สินค้าของเรา สินค้าของเรา
- สั่งซื้อ สั่งซื้อ
- วิธีการสั่งซื้อ วิธีการสั่งซื้อ
- ข่าวสารและกิจกรรม ข่าวสารและกิจกรรม
- ติดต่อเรา ติดต่อเรา



